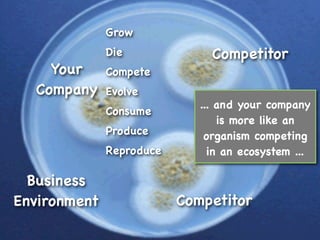
Grow
              Die              Competitor
    Your      Compete
  Company     Evolve
                             ... and your company
              Consume
                                 is more like an
              Produce         organism competing
              Reproduce        in an ecosystem ...

  Business
Environment               Competitor

The document summarizes a tutorial on the evolving relationship between business and IT, highlighting the impacts of consumerization and technological change. It discusses innovation, commoditization, and the necessity for organizations to adapt their management and operational strategies in response to evolving ecosystems. The session emphasizes the importance of understanding these dynamics to maintain competitive advantage and manage complexity effectively.